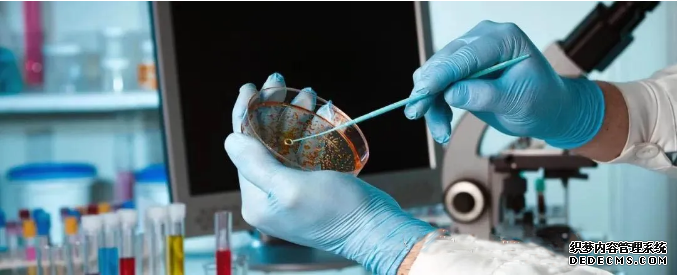

動物實驗室消毒專家“奧克泰士”
發(fā)布時(shí)間:2021-05-27浏覽次數:文章來源:未知
實驗室的消毒滅菌工作十分重要,自然需要用到消毒藥劑。市場上消毒産品種(zhǒng)類繁多,每一種(zhǒng)産品貌似都(dōu)可以達到良好(hǎo)的消毒效果,但實際使用之後(hòu)卻暴露出各種(zhǒng)意料之外的缺陷。這(zhè)就(jiù)需要實驗室從業人員對(duì)各種(zhǒng)消毒産品有一定程度的了解,根據實驗室的現場條件和需求選擇最合适的消毒産品,其實這(zhè)是一項十分艱難的選擇。




(高倍顯微鏡下消毒不幹淨黴菌滋生過(guò)程)

01.目前常用的消毒産品類型:
常見成(chéng)分:醇類、醛類、季铵鹽化合物、戊二醛、胍類、過(guò)氧化氫、過(guò)氧乙酸以及新型過(guò)氧化氫銀離子(德國(guó)Oxytech)等。市場上的消毒産品種(zhǒng)類很多,每種(zhǒng)消毒産品也各有自己的優勢和不足,在這(zhè)種(zhǒng)情況下了解消毒産品特性,根據自身的消毒要求選擇最适合的産品十分重要。

02.德國(guó)第三方實驗室對(duì)常見消毒産品評估:
上表爲對(duì)常見消毒産品的多個參數進(jìn)行的評估和計分。最好(hǎo)的或最理想的計2分,用綠色标識;中等或适度的計1分,用黃色标識;最差的或無效的計0分,用紅色标識。從結果來看,Oxytech/奧克泰士得到22分的評估,遠高于其它成(chéng)分的消毒劑。將(jiāng)奧克泰士進(jìn)行30%比例稀釋液的評分依然能(néng)達到20分。

03.對(duì)高抗性微生物的殺滅率:
黴菌、芽孢和病毒是微生物中抗性高的種(zhǒng)類,特别是芽孢的抗性最高。制藥、實驗室、醫療等場所往往以芽孢作爲标準,來選擇化學(xué)滅菌劑。化學(xué)滅菌劑(chemisterilants)是指用作滅菌的化學(xué)物質,滅菌以能(néng)否殺滅細菌芽孢爲标準,能(néng)夠高效殺滅芽孢(Spores)的化學(xué)試劑叫(jiào)做孢子滅菌劑,在國(guó)内又常稱爲殺孢子劑。

從消毒産品評估表中可以看到,對(duì)黴菌、芽孢和病毒都(dōu)具有理想效果的是過(guò)氧乙酸和奧克泰士,這(zhè)兩(liǎng)種(zhǒng)也是目前制藥等行業采用的殺孢子劑。過(guò)氧乙酸也具有優良的殺菌效果,但毒性和刺激性較大,對(duì)金屬等材料腐蝕較大。奧克泰士能(néng)夠快速殺黴菌、芽孢與病毒,殺菌譜覆蓋所有類型微生物,殺菌譜無間隙無盲區。奧克泰士無色無味,沒(méi)有毒性和腐蝕性,是一種(zhǒng)未來趨勢型的殺孢子劑和日常消毒劑。
(高倍顯微鏡下消毒不幹淨黴菌滋生過(guò)程)


04.Oxytech/奧克泰士國(guó)際品質的生态消毒專家
奧克泰士是無色無味,透明液體,完全溶于水,可以用噴灑、擦拭和浸泡的方式,對(duì)各種(zhǒng)材料的物表和空氣進(jìn)行消毒滅菌。

上一篇:獸醫随筆:實驗動物食物控制